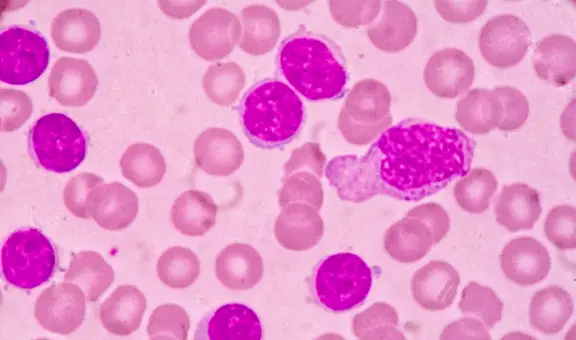
Píldora experimental consigue la remisión completa del cáncer en 18 pacientes con leucemia resistente

Científicos detectan cafeína oculta en populares bebidas consumidas en Perú
De las 30 muestras en las que detectaron cafeína, solo 2 marcas declararon este contenido.
- Sorpresa en la comunidad científica: nace la primera cría en libertad de un animal desaparecido de su hábitat tras más de 100 años
- Los arqueólogos quedaron sorprendidos cuando abrieron la tapa de un sarcófago romano sellado de 1.700 años de antiguedad

La presencia de la cafeína en bebidas populares es un tema que se ha estudiado en otros países y que resulta importante conocer debido a los efectos que produce su consumo excesivo en el sistema nervioso central. Por ello, un grupo de investigadores decidió analizar distintos grupos de bebidas comercializadas en el país.
Como referencia, los investigadores consideraron un estudio hecho en Serbia que analizó un aproximado de 21 bebidas y comparó los niveles de cafeína consignados en la información nutricional del producto con sus hallazgos en el laboratorio. Tomando esto como precedente, la idea del equipo de Reátegui fue identificar si existía una correlación entre la información presente en las etiquetas y los valores reales de las bebidas.
“Algo interesante es que, a diferencia de otros países, en Perú no todas las marcas declaran la presencia de cafeína como componente. De nuestras 30 muestras, solamente dos marcas lo declararon. En el caso de Serbia, nuestro principal antecedente del estudio, se identificó una cantidad mayor: de 21 muestras, 11 declararon. Es un asunto curioso porque se trata de marcas internacionales presentes en ambos países”, explica Óscar Reátegui, investigador de la Universidad Científica del Sur y autor principal del estudio.
“Otro artículo relacionado de Estados Unidos señalaba también que tanto niños, adolescentes y adultos consumían cafeína de bebidas como té, gaseosas, leche chocolatadas y bebidas energizantes. Esto nos pareció interesante porque implica que bebidas comunes tienen presencia de componentes de consumo infantil que no han sido declarados”, añade.
El estudio fue publicado en la revista científica international Journal of Food Science en enero de 2023, indexada en Scopus.
¿Cómo se hizo el estudio y qué hallaron?
Para el desarrollo de la investigación, además de considerar estudios previos, los investigadores realizaron una encuesta para identificar las bebidas que tenían un mayor consumo por los peruanos. Asimismo, estos productos se agruparon en seis categorías: infusiones, café en polvo, leches con chocolate, refrescos, bebidas deportivas y bebidas energéticas.
Para el análisis, los científicos utilizaron la técnica de cromatografía básica, en la cual se utiliza una muestra con varios componentes que se dividen para efectuar el estudio. “Es una técnica muy confiable. Nosotros en la Universidad Científica contamos con el equipo de análisis y nos ha permitido determinar el contenido de estas tres moléculas en las bebidas”, detalla Reátegui.
La investigación identificó principalmente la presencia de cafeína en cinco de los seis grupos de bebidas examinados. “Encontramos cafeína en diversos grupos de bebidas, especialmente energizantes. La cantidad aproximada que presentaban las bebidas era de 190 a 200 miligramos cada una. Esto se daba en cinco grupos de bebidas, exceptuando las bebidas rehidratantes”, detalla Gonzales.
¿Cuáles son las cantidades ideales de cafeína que debemos consumir?
Los especialistas señalan que la cantidad ideal de cafeína que se debe consumir es menor a 400 miligramos al día en adultos, considerando que cada día podemos consumir diferentes bebidas que contengan este compuesto. “La cantidad de café recomendada no debe superar las tres tazas. Desde cuatro tazas a más, se genera un riesgo, especialmente en los grupos que son vulnerables o sensibles, como niños y adolescentes. En el caso de embarazadas, esto se debe limitar completamente”, detalla Gonzales.
Es así como la ingesta de cafeína debe ser controlada en todas sus presentaciones. “En nuestro día a día buscamos siempre mantenernos activos por temas de estrés y consumimos energizantes a mayor escala y café sin tener el conocimiento de la cantidad de cafeína que incorporamos porque no se da esa información en el etiquetado nutricional, lamentablemente”, advierte.
Una problemática para la salud
La carencia y falta de transparencia de información respecto a los componentes de las bebidas podrían perjudicar a la población que las consumen. “En Perú no se está declarando de forma transparente la presencia de ciertos componentes en las bebidas. Es importante en ese sentido fortalecer las normas técnicas y el etiquetado nutricional de los productos con estos hallazgos”, recomienda Óscar Reátegui.
“No se trata de satanizar componentes como la cafeína. Por supuesto que tiene sus ventajas, siempre y cuando no se consuman en excesos. Sabemos que, por un tema de practicidad, las personas prefieren bebidas listas para consumir y, en ese sentido, es clave que cuenten con toda la información de lo que están tomando”, finaliza.